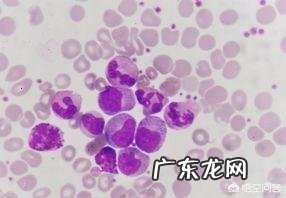
血常规检查主要查哪几项?

⑵减少:①各种原因出血(红细胞丢失过多),②各种原因溶血(红细胞寿命缩短),③各种贫血、白血病、甲状腺功能亢进,④慢性肾衰竭,服用某些药物(抗肿瘤药、磺胺类药)
二、血红蛋白(Hb):是红细胞主要组成部分,承担运输氧气和二氧化碳的功能 。
正常范围:
男性120~170g/L
女性110~150g/L
新生儿170~200g/L
临床意义:
血红蛋白(Hb)增减的临床意义与红细胞基本相同,但血红蛋白更能反应贫血程度,贫血程度可分为:1.轻度贫血:Hb低于正常值下限,>90g/L,2.中度贫血:Hb在60~90g/L,3.重度贫血:Hb在60~60g/L,4.极重度贫血:Hb在30g/L以下 。
三、白细胞计数(WBC):指单位体积中所含有的白细胞数目 。
文章插图
正常范围:
成人(4.0~10.0)×109/L
新生儿(15.0~20.0)×109/L
临床意义:
1.生理性变化:增多:①新生儿、剧烈运动、妊娠、情绪激动,
2.病理性变化:⑴增多:①急性感染或炎症(细菌感染、病毒感染和寄生虫感染),②广泛组织损伤或坏死,③急性溶血和急性失血,④急性中毒和恶性肿瘤,
⑵减少:①感染(伤寒、副伤寒和流感),②再生障碍性贫血,③脾功能亢进,④放疗化疗,
四、白细胞分类计数(DC)指各类白细胞分别计数并计算的比值或百分比 。

文章插图

文章插图
正常范围:
中性粒细胞(Neu):(2.00~7.00)×109/L或50%~70%
嗜酸性粒细胞(Eos):(0.02~0.50)×109/L或0.5%~5%
嗜碱性粒细胞(Bas):(0.00~0.10)×109/L或0~1%
淋巴细胞(Lym):(0.80~4.00)×109/L或20%~40%
单核细胞(Mon):(0.12~1.00)×109/L或3%~10%
临床意义:
1.中性粒细胞:因中性粒细胞占白细胞总数的50%~70%,所以其增减的临床意义与白细胞计数基本一致,
2.嗜酸性粒细胞:⑴增多见于寄生虫病、过敏性疾病、皮肤病、肿瘤、血液病和脾切除后,
⑵减少见于手术和烧伤患者的观察及预后、伤寒和副伤寒,
3.嗜碱性粒细胞:⑴增多见于慢性粒细胞白血病、恶性肿瘤、过敏性疾病,
⑵减少见于速发性过敏反应、肾上腺皮质激素使用过量等,
4.淋巴细胞:⑴增多见于急性传染病、结核、肾移植后、白血病等,
⑵减少见于严重化脓性感染、传染病急性期、长期使用肾上腺皮质激素、接触放射线等,
5.单核细胞:⑴生理性增多见于出生后2周内的婴儿生理性增多、儿童较成人稍多、妊娠时生理性增多,
⑵病理性增多见某些感染和急性感染恢复期、活动性肺结核、单核细胞白血病等,
五、血小板计算(PLT)指单位体积中所含有的血小板数目 。

文章插图
正常范围:
(100~300)×109/L
临床意义:
1.血小板计数增多见于大出血和手术后、原发性血小板增多症、多发性骨髓瘤等,
2.血小板计数减少见于脾功能亢进、再生障碍性贫血、弥散性血管内凝血等,
喜欢的关注一下,分享更多检验知识 。谢谢!
选择权威科普,享受健康生活,欢迎关注医学博士团队!

文章插图
血常规是我们去医院就诊时最常见的检查 。一般去医院呼吸内科,血液内科就诊或住院检查中医生都会开具血常规检查单,目的就是要通过血常规的检查结果来了解患者的身体状况,根据血常规检查报告单中的相关指标来分析病因,辅助诊断,进而指导下一步诊治方案的制定 。
- 流出的姨妈有血块是否暗示血瘀严重?
- o型血爸爸的孩子是什么血型?
- 有一个朋友好不容易怀孕,去检查医生说生化了,她还能再要吗?
- 澳大利亚科学家说高胆固醇和心脑血管疾病发病无关,真的如此吗?
- 降血糖的十种最佳食物
- 肾功能检查应该做哪些项目?
- 高血压能吃西瓜吗
- 流鼻血是什么原因?
- 恭喜EDG,再见777!EDG常规赛完美收官,厂长因0次登场将无缘季后赛,他真的不上场了吗?
- 男性生殖4项都检查什么?
特别声明:本站内容均来自网友提供或互联网,仅供参考,请勿用于商业和其他非法用途。如果侵犯了您的权益请与我们联系,我们将在24小时内删除。
